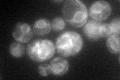
YKL154W
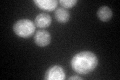
YKL154W
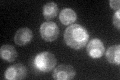
YKL154W
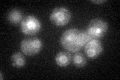
YKL154W

View description
Signal recognition particle (SRP) receptor beta subunit; involved in SRP-dependent protein targeting; anchors Srp101p to the ER membrane
Localization:
Intensity:
Fold change:
Significance:
-
C’ GFP library in SD
ER47.93 -
N' NOP1pr-GFP in SD

N/A0 -
N' TEF2pr-mCherry in SD

N/A0 -
N' NATIVEpr-GFP in SD

N/A0 -
N' TEF2pr-VC and Cyto-VN in SD

N/A0 -
C’ GFP library in SD+DTT
ER40.090.83No -
C’ GFP library in SD+H2O2
ER47.020.98No -
C’ GFP library in Starvation Media
ER62.221.29No -
C’ GFP library on the background of Pup2-DaMP

ER -
C’ GFP library on the background of CCT mutant

ER44.65390.931455No
